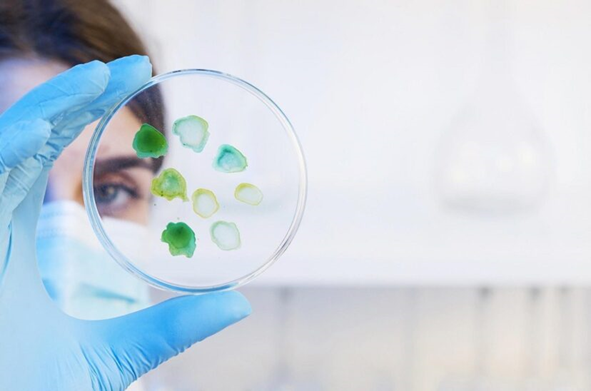

SENA y UFPS se unen para innovar en el Catatumbo
SENA y UFPS se unen para innovar en el Catatumbo En una nueva alianza realizada por el SENA y la universidad Francisco de Paula Santander el nuevo proyecto busca ofrecer a los estudiantes la oportunidad de demostrar sus habilidades en diversos campos de investigación. El esfuerzo conjunto se desarrolla con…